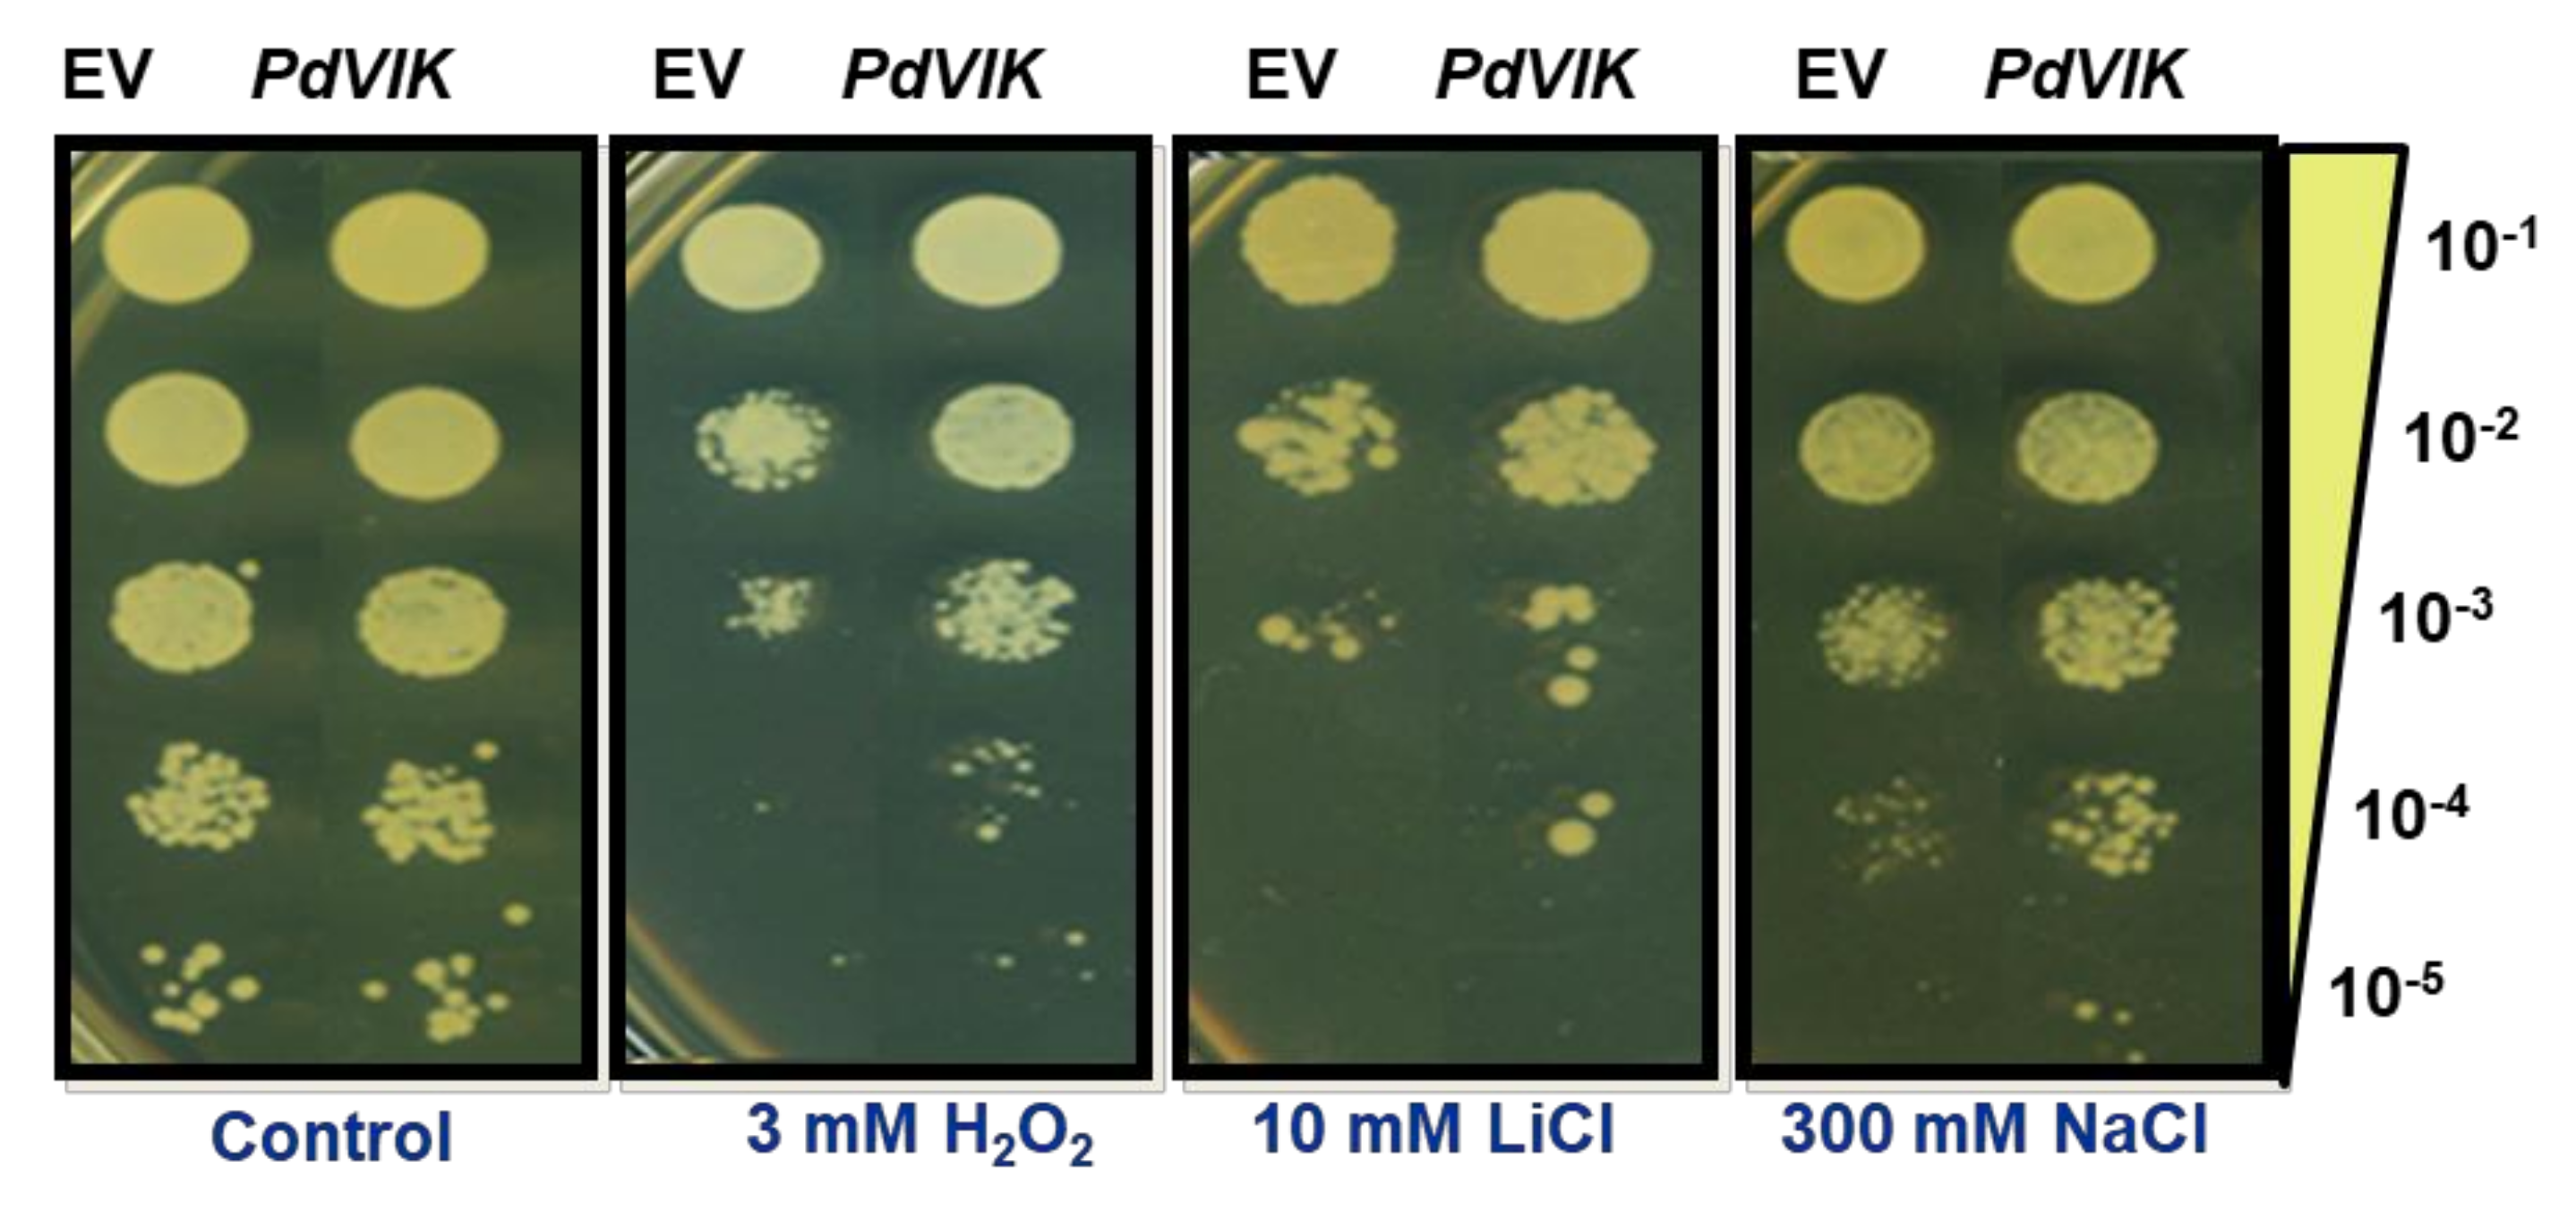
Genes 11 00568 g004 Genes 11 00568 g004

Molecular Characterization of a Date Palm Vascular Highway 1-Interacting Kinase (PdVIK) under Abiotic Stresses
Abstract
1. Introduction
2. Materials and Methods
2.1. In Silico Protein Sequence Analysis
2.2. In-Silico Analysis of the Putative Promoter Sequences of the Kinase Genes
2.3. Production of Recombinant PdVIK Protein in E. coli
2.4. Enzymatic Phosphorylation Activity Assay of PdVIK
2.5. Molecular Cloning and Heterologous Expression of PdVIK in Yeast
2.6. Functional Yeast Spot Assay
2.7. Cation Sensitivity Assay
2.8. Intracellular Measurement of Na+ and K+ Ions in Yeast Cells
2.9. Cloning and Heterologous Expression of PdVIK in Arabidopsis
2.10. Stress Tolerance Analysis of PdVIK Transgenic Arabidopsis Lines on MS Medium
2.11. Stress Tolerance Analysis of Soil-Grown PdVIK Transgenic Lines
2.12. Estimation of Na+ and K+ Levels in Arabidopsis Plants
2.13. Protein Extraction from Plants and Western Blotting
2.14. Statistical Analysis
3. Results
3.1. Date Palm Genome Encodes Ten Families of Protein Kinase Genes
3.2. PdVIK Exhibited Tyrosine Phosphorylation Activity
3.3. Expression of PdVIK in Yeast Enhanced Growth Under Abiotic Stress Conditions
3.4. The Transgenic Arabidopsis Seedlings Maintained Better Root Growth Under Stress Conditions
3.5. Soil Grown PdVIK Transgenic Lines Showed Modulated Responses to Salinity and Drought
4. Discussion
5. Conclusions
Supplementary Materials
Author Contributions
Funding
Acknowledgments
Conflicts of Interest
References
- Wang, W.; Vinocur, B.; Altman, A. Plant responses to drought, salinity and extreme temperatures: Towards genetic engineering for stress tolerance. Planta 2003, 218, 1–14. [Google Scholar] [CrossRef] [PubMed]
- Munns, R.; Gilliham, M. Salinity tolerance of crops–what is the cost? New Phytol. 2015, 208, 668–673. [Google Scholar] [CrossRef] [PubMed]
- Tyerman, S.D.; Munns, R.; Fricke, W.; Arsova, B.; Barkla, B.J.; Bose, J.; Bramley, H.; Byrt, C.; Chen, Z.; Colmer, T.D. Energy costs of salinity tolerance in crop plants. New Phytol. 2019, 221, 25–29. [Google Scholar] [CrossRef] [PubMed]
- Panta, S.; Lane, P.; Doyle, R.; Hardie, M.; Haros, G.; Shabala, S. Halophytes as a possible alternative to desalination plants: Prospects of recycling saline wastewater during Coal Seam Gas operations. In Halophytes for Food Security in Dry Lands; Elsevier: Amsterdam, The Netherlands, 2016; pp. 317–329. [Google Scholar]
- Zhang, H.; Han, B.; Wang, T.; Chen, S.; Li, H.; Zhang, Y.; Dai, S. Mechanisms of plant salt response: Insights from proteomics. J. Proteome Res. 2011, 11, 49–67. [Google Scholar] [CrossRef] [PubMed]
- Al-Harrasi, I.; Al-Yahyai, R.; Yaish, M.W. Differential DNA methylation and transcription profiles in date palm roots exposed to salinity. PLoS ONE 2018, 13, e0191492. [Google Scholar] [CrossRef] [PubMed]
- Assaha, D.V.; Ueda, A.; Saneoka, H.; Al-Yahyai, R.; Yaish, M.W. The role of Na+ and K+ transporters in salt stress adaptation in glycophytes. Front. Physiol. 2017, 8, 509. [Google Scholar] [CrossRef]
- Al Kharusi, L.; Al Yahyai, R.; Yaish, M.W. Antioxidant Response to Salinity in Salt-Tolerant and Salt-Susceptible Cultivars of Date Palm. Agriculture 2019, 9, 8. [Google Scholar] [CrossRef]
- Patankar, H.V.; Al-Harrasi, I.; Al-Yahyai, R.; Yaish, M.W. Functional Characterization of Date Palm Aquaporin Gene PdPIP1; 2 Confers Drought and Salinity Tolerance to Yeast and Arabidopsis. Genes 2019, 10, 390. [Google Scholar] [CrossRef]
- Zhang, F.; Zhu, G.; Du, L.; Shang, X.; Cheng, C.; Yang, B.; Hu, Y.; Cai, C.; Guo, W. Genetic regulation of salt stress tolerance revealed by RNA-Seq in cotton diploid wild species, Gossypium davidsonii. Sci. Rep. 2016, 6, 20582. [Google Scholar] [CrossRef]
- Ho, H.L. Plant Protein Kinase and Protein-Protein Interaction. Biodivers. Bioprospect. Dev. 2015, 2, 1–15. [Google Scholar]
- Shchemelinin, I.; Sefc, L.; Necas, E. Protein kinases, their function and implication in cancer and other diseases. Folia Biol. 2006, 52, 81. [Google Scholar]
- Becraft, P.W. Receptor kinase signaling in plant development. Annu. Rev. Cell Dev. Biol. 2002, 18, 163–192. [Google Scholar] [CrossRef] [PubMed]
- Afzal, A.J.; Wood, A.J.; Lightfoot, D.A. Plant receptor-like serine threonine kinases: Roles in signaling and plant defense. Mol. Plant Microbe Interact. 2008, 21, 507–517. [Google Scholar] [CrossRef] [PubMed]
- Ligterink, W.; Hirt, H. Mitogen-activated protein (MAP) kinase pathways in plants: Versatile signaling tools. Int. Rev. Cytol. 2001, 201, 209–258. [Google Scholar] [PubMed]
- Qiu, Q.-S.; Guo, Y.; Quintero, F.J.; Pardo, J.M.; Schumaker, K.S.; Zhu, J.-K. Regulation of vacuolar Na+/H+ exchange in Arabidopsis thaliana by the salt-overly-sensitive (SOS) pathway. J. Biol. Chem. 2004, 279, 207–215. [Google Scholar] [CrossRef] [PubMed]
- Zhu, J.-K. Regulation of ion homeostasis under salt stress. Curr. Opin. Plant Biol. 2003, 6, 441–445. [Google Scholar] [CrossRef]
- Diédhiou, C.J.; Popova, O.V.; Dietz, K.-J.; Golldack, D. The SNF1-type serine-threonine protein kinase SAPK4 regulates stress-responsive gene expression in rice. BMC Plant Biol. 2008, 8, 49. [Google Scholar] [CrossRef]
- Borkiewicz, L.; Polkowska-Kowalczyk, L.; Cieśla, J.; Sowiński, P.; Jończyk, M.; Rymaszewski, W.; Szymańska, K.P.; Jaźwiec, R.; Muszyńska, G.; Szczegielniak, J. Expression of maize Calcium-Dependent Protein Kinase (ZmCPK11) improves salt tolerance in transgenic Arabidopsis plants by regulating sodium and potassium homeostasis and stabilizing photosystem II. Physiol. Plant. 2020, 168, 38–57. [Google Scholar] [CrossRef]
- Yaish, M.W.; Kumar, P.P. Salt tolerance research in date palm tree (Phoenix dactylifera L.), past, present, and future perspectives. Front. Plant Sci. 2015, 6, 348. [Google Scholar] [CrossRef]
- Yaish, M.W.; Sunkar, R.; Zheng, Y.; Ji, B.; Al-Yahyai, R.; Sardar, F.A. A genome-wide identification of the miRNAome in response to salinity stress in date palm (Phoenix dactylifera L.). Front. Plant Sci. 2015, 6. [Google Scholar] [CrossRef]
- Mizoguchi, T.; Irie, K.; Hirayama, T.; Hayashida, N.; Yamaguchi-Shinozaki, K.; Matsumoto, K.; Shinozaki, K. A gene encoding a mitogen-activated protein kinase kinase kinase is induced simultaneously with genes for a mitogen-activated protein kinase and an S6 ribosomal protein kinase by touch, cold, and water stress in Arabidopsis thaliana. Proc. Natl. Acad. Sci. USA 1996, 93, 765–769. [Google Scholar] [CrossRef] [PubMed]
- Barajas-Lopez, J.d.D.; Moreno, J.R.; Gamez-Arjona, F.M.; Pardo, J.M.; Punkkinen, M.; Zhu, J.K.; Quintero, F.J.; Fujii, H. Upstream kinases of plant Sn RK s are involved in salt stress tolerance. Plant J. 2018, 93, 107–118. [Google Scholar] [CrossRef] [PubMed]
- Xiong, L.; Yang, Y. Disease resistance and abiotic stress tolerance in rice are inversely modulated by an abscisic acid–inducible mitogen-activated protein kinase. Plant Cell 2003, 15, 745–759. [Google Scholar] [CrossRef] [PubMed]
- Ovečka, M.; Takáč, T.; Komis, G.; Vadovič, P.; Bekešová, S.; Doskočilová, A.; Smékalová, V.; Luptovčiak, I.; Šamajová, O.; Schweighofer, A. Salt-induced subcellular kinase relocation and seedling susceptibility caused by overexpression of Medicago SIMKK in Arabidopsis. J. Exp. Bot. 2014, 65, 2335–2350. [Google Scholar] [CrossRef]
- Zhang, H.; Mao, X.; Wang, C.; Jing, R. Overexpression of a common wheat gene TaSnRK2. 8 enhances tolerance to drought, salt and low temperature in Arabidopsis. PLoS ONE 2010, 5, e16041. [Google Scholar] [CrossRef]
- Zhao, J.; Gao, Y.; Zhang, Z.; Chen, T.; Guo, W.; Zhang, T. A receptor-like kinase gene (GbRLK) from Gossypium barbadense enhances salinity and drought-stress tolerance in Arabidopsis. BMC Plant Biol. 2013, 13, 110. [Google Scholar] [CrossRef]
- Patankar, H.V.; Al-Harrasi, I.; Al-Yahyai, R.; Yaish, M.W. Identification of Candidate Genes Involved in the Salt Tolerance of Date Palm (Phoenix dactylifera L.) Based on a Yeast Functional Bioassay. DNA Cell Biol. 2018, 37, 524–534. [Google Scholar] [CrossRef]
- Ye, J.; Yang, H.; Shi, H.; Wei, Y.; Tie, W.; Ding, Z.; Yan, Y.; Luo, Y.; Xia, Z.; Wang, W.; et al. The MAPKKK gene family in cassava: Genome-wide identification and expression analysis against drought stress. Sci. Rep. 2017, 7, 14939. [Google Scholar] [CrossRef]
- Ceserani, T.; Trofka, A.; Gandotra, N.; Nelson, T. VH1/BRL2 receptor-like kinase interacts with vascular-specific adaptor proteins VIT and VIK to influence leaf venation. Plant J. 2009, 57, 1000–1014. [Google Scholar] [CrossRef]
- Yaish, M.W.; Patankar, H.V.; Assaha, D.V.; Zheng, Y.; Al-Yahyai, R.; Sunkar, R. Genome-wide expression profiling in leaves and roots of date palm (Phoenix dactylifera L.) exposed to salinity. BMC Genom. 2017, 18, 246. [Google Scholar] [CrossRef]
- Feng, D.-F.; Doolittle, R.F. Progressive sequence alignment as a prerequisitetto correct phylogenetic trees. J. Mol. Evol. 1987, 25, 351–360. [Google Scholar] [CrossRef] [PubMed]
- Kumar, S.; Stecher, G.; Tamura, K. MEGA7: Molecular evolutionary genetics analysis version 7.0 for bigger datasets. Mol. Biol. Evol. 2016, 33, 1870–1874. [Google Scholar] [CrossRef] [PubMed]
- Bailey, T.L.; Boden, M.; Buske, F.A.; Frith, M.; Grant, C.E.; Clementi, L.; Ren, J.; Li, W.W.; Noble, W.S. MEME SUITE: Tools for motif discovery and searching. Nucleic Acids Res. 2009, 37, W202–W208. [Google Scholar] [CrossRef] [PubMed]
- Sigrist, C.J.; De Castro, E.; Cerutti, L.; Cuche, B.A.; Hulo, N.; Bridge, A.; Bougueleret, L.; Xenarios, I. New and continuing developments at PROSITE. Nucleic Acids Res. 2012, 41, D344–D347. [Google Scholar] [CrossRef] [PubMed]
- Gasteiger, E.; Gattiker, A.; Hoogland, C.; Ivanyi, I.; Appel, R.D.; Bairoch, A. ExPASy: The proteomics server for in-depth protein knowledge and analysis. Nucleic Acids Res. 2003, 31, 3784–3788. [Google Scholar] [CrossRef] [PubMed]
- Kyte, J.; Doolittle, R.F. A simple method for displaying the hydropathic character of a protein. J. Mol. Biol. 1982, 157, 105–132. [Google Scholar] [CrossRef]
- Rombauts, S.; Déhais, P.; Van Montagu, M.; Rouzé, P. PlantCARE, a plant cis-acting regulatory element database. Nucleic Acids Res. 1999, 27, 295–296. [Google Scholar] [CrossRef]
- Abràmoff, M.D.; Magalhães, P.J.; Ram, S.J. Image processing with ImageJ. Biophotonics Int. 2004, 11, 36–42. [Google Scholar]
- Petrezselyova, S.; Kinclova-Zimmermannova, O.; Sychrova, H. Vhc1, a novel transporter belonging to the family of electroneutral cation–Cl− cotransporters, participates in the regulation of cation content and morphology of Saccharomyces cerevisiae vacuoles. Biochim. Biophys. Acta Biomembr. 2013, 1828, 623–631. [Google Scholar] [CrossRef]
- Mekawy, A.M.M.; Assaha, D.V.; Munehiro, R.; Kohnishi, E.; Nagaoka, T.; Ueda, A.; Saneoka, H. Characterization of type 3 metallothionein-like gene (OsMT-3a) from rice, revealed its ability to confer tolerance to salinity and heavy metal stresses. Environ. Exp. Bot. 2018, 147, 157–166. [Google Scholar] [CrossRef]
- Clough, S.J.; Bent, A.F. Floral dip: A simplified method for Agrobacterium-mediated transformation of Arabidopsis thaliana. Plant J. 1998, 16, 735–743. [Google Scholar] [CrossRef] [PubMed]
- Arnon, D.I. Copper Enzymes in Isolated Chloroplasts. Polyphenoloxidase in Beta Vulgaris. Plant Physiol. 1949, 24, 1–15. [Google Scholar] [CrossRef] [PubMed]
- Mullan, D.; Pietragalla, J. Leaf relative water content. Physiological Breeding II: A Field Guide to Wheat Phenotyping; CIMMYT: Texcoco, Mexico, 2012; pp. 25–27. [Google Scholar]
- Bates, L.S.; Waldren, R.P.; Teare, I. Rapid determination of free proline for water-stress studies. Plant Soil 1973, 39, 205–207. [Google Scholar] [CrossRef]
- Patankar, H.V.; Al-Harrasi, I.; Al Kharusi, L.; Jana, G.A.; Al-Yahyai, R.; Sunkar, R.; Yaish, M.W. Overexpression of a Metallothionein 2A Gene from Date Palm Confers Abiotic Stress Tolerance to Yeast and Arabidopsis thaliana. Int. J. Mol. Sci. 2019, 20, 2871. [Google Scholar] [CrossRef]
- Munns, R.; Wallace, P.A.; Teakle, N.L.; Colmer, T.D. Measuring soluble ion concentrations (Na+, K+, Cl−) in salt-treated plants. In Plant Stress Tolerance; Springer: Berlin, Germany, 2010; pp. 371–382. [Google Scholar]
- Ho, H.L. Functional roles of plant protein kinases in signal transduction pathways during abiotic and biotic stress. J. Biodivers. Bioprospect. Dev. 2015, 2, 147. [Google Scholar]
- Murphy, F.; He, Q.; Armstrong, M.; Giuliani, L.M.; Boevink, P.C.; Zhang, W.; Tian, Z.; Birch, P.R.; Gilroy, E.M. The potato MAP3K StVIK is required for the Phytophthora infestans RXLR effector Pi17316 to promote disease. Plant Physiol. 2018, 177, 398–410. [Google Scholar] [CrossRef]
- Roskoski, R. Enzyme Structure and Function. In Reference Module in Biomedical Sciences; Elsevier: Amsterdam, The Netherlands, 2014. [Google Scholar] [CrossRef]
- Bartels, D.; Sunkar, R. Drought and salt tolerance in plants. Crit. Rev. Plant Sci. 2005, 24, 23–58. [Google Scholar] [CrossRef]
- Zorina, A.; Bedbenov, V.; Novikova, G.; Panichkin, V. Involvement of serine/threonine protein kinases in the cold stress response in the cyanobacterium Synechocystis sp. PCC 6803: Functional characterization of SpkE protein kinase. Mol. Biol. 2014, 48, 390–398. [Google Scholar] [CrossRef]
- Kobe, B.; Kampmann, T.; Forwood, J.K.; Listwan, P.; Brinkworth, R.I. Substrate specificity of protein kinases and computational prediction of substrates. Biochim. Biophys. Acta Proteins Proteom. 2005, 1754, 200–209. [Google Scholar] [CrossRef]
- Reddy, M.M.; Rajasekharan, R. Serine/threonine/tyrosine protein kinase from Arabidopsis thaliana is dependent on serine residues for its activity. Arch. Biochem. Biophys. 2007, 460, 122–128. [Google Scholar] [CrossRef]
- Calero, F.; Gómez, N.; Ariño, J.; Ramos, J. Trk1 and Trk2 define the major K+ transport system in fission yeast. J. Bacteriol. 2000, 182, 394–399. [Google Scholar] [CrossRef] [PubMed]
- Mulet, J.M.; Leube, M.P.; Kron, S.J.; Rios, G.; Fink, G.R.; Serrano, R. A novel mechanism of ion homeostasis and salt tolerance in yeast: The Hal4 and Hal5 protein kinases modulate the Trk1-Trk2 potassium transporter. Mol. Cell. Biol. 1999, 19, 3328–3337. [Google Scholar] [CrossRef] [PubMed]
- Wang, J.; Liu, S.; Li, C.; Wang, T.; Zhang, P.; Chen, K. PnLRR-RLK27, a novel leucine-rich repeats receptor-like protein kinase from the Antarctic moss Pohlia nutans, positively regulates salinity and oxidation-stress tolerance. PLoS ONE 2017, 12, e0172869. [Google Scholar] [CrossRef] [PubMed]
- Pitzschke, A.; Schikora, A.; Hirt, H. MAPK cascade signalling networks in plant defence. Curr. Opin. Plant Biol. 2009, 12, 421–426. [Google Scholar] [CrossRef]
- Ichimura, K.; Tena, G.; Henry, Y.; Zhang, S.; Hirt, H.; Ellis, B.E.; Morris, P.C.; Wilson, C.; Champion, A.; Innes, R.W.; et al. Mitogen-activated protein kinase cascades in plants: A new nomenclature. Trends Plant Sci. 2002, 7, 301–308. [Google Scholar]

© 2020 by the authors. Licensee MDPI, Basel, Switzerland. This article is an open access article distributed under the terms and conditions of the Creative Commons Attribution (CC BY) license (http://creativecommons.org/licenses/by/4.0/).
Share and Cite
Al-Harrasi, I.; Patankar, H.V.; Al-Yahyai, R.; Sunkar, R.; Krishnamurthy, P.; Kumar, P.P.; Yaish, M.W. Molecular Characterization of a Date Palm Vascular Highway 1-Interacting Kinase (PdVIK) under Abiotic Stresses. Genes 2020, 11, 568. https://doi.org/10.3390/genes11050568
Al-Harrasi I, Patankar HV, Al-Yahyai R, Sunkar R, Krishnamurthy P, Kumar PP, Yaish MW. Molecular Characterization of a Date Palm Vascular Highway 1-Interacting Kinase (PdVIK) under Abiotic Stresses. Genes. 2020; 11(5):568. https://doi.org/10.3390/genes11050568
Chicago/Turabian StyleAl-Harrasi, Ibtisam, Himanshu V. Patankar, Rashid Al-Yahyai, Ramanjulu Sunkar, Pannaga Krishnamurthy, Prakash P. Kumar, and Mahmoud W. Yaish. 2020. "Molecular Characterization of a Date Palm Vascular Highway 1-Interacting Kinase (PdVIK) under Abiotic Stresses" Genes 11, no. 5: 568. https://doi.org/10.3390/genes11050568
APA StyleAl-Harrasi, I., Patankar, H. V., Al-Yahyai, R., Sunkar, R., Krishnamurthy, P., Kumar, P. P., & Yaish, M. W. (2020). Molecular Characterization of a Date Palm Vascular Highway 1-Interacting Kinase (PdVIK) under Abiotic Stresses. Genes, 11(5), 568. https://doi.org/10.3390/genes11050568

